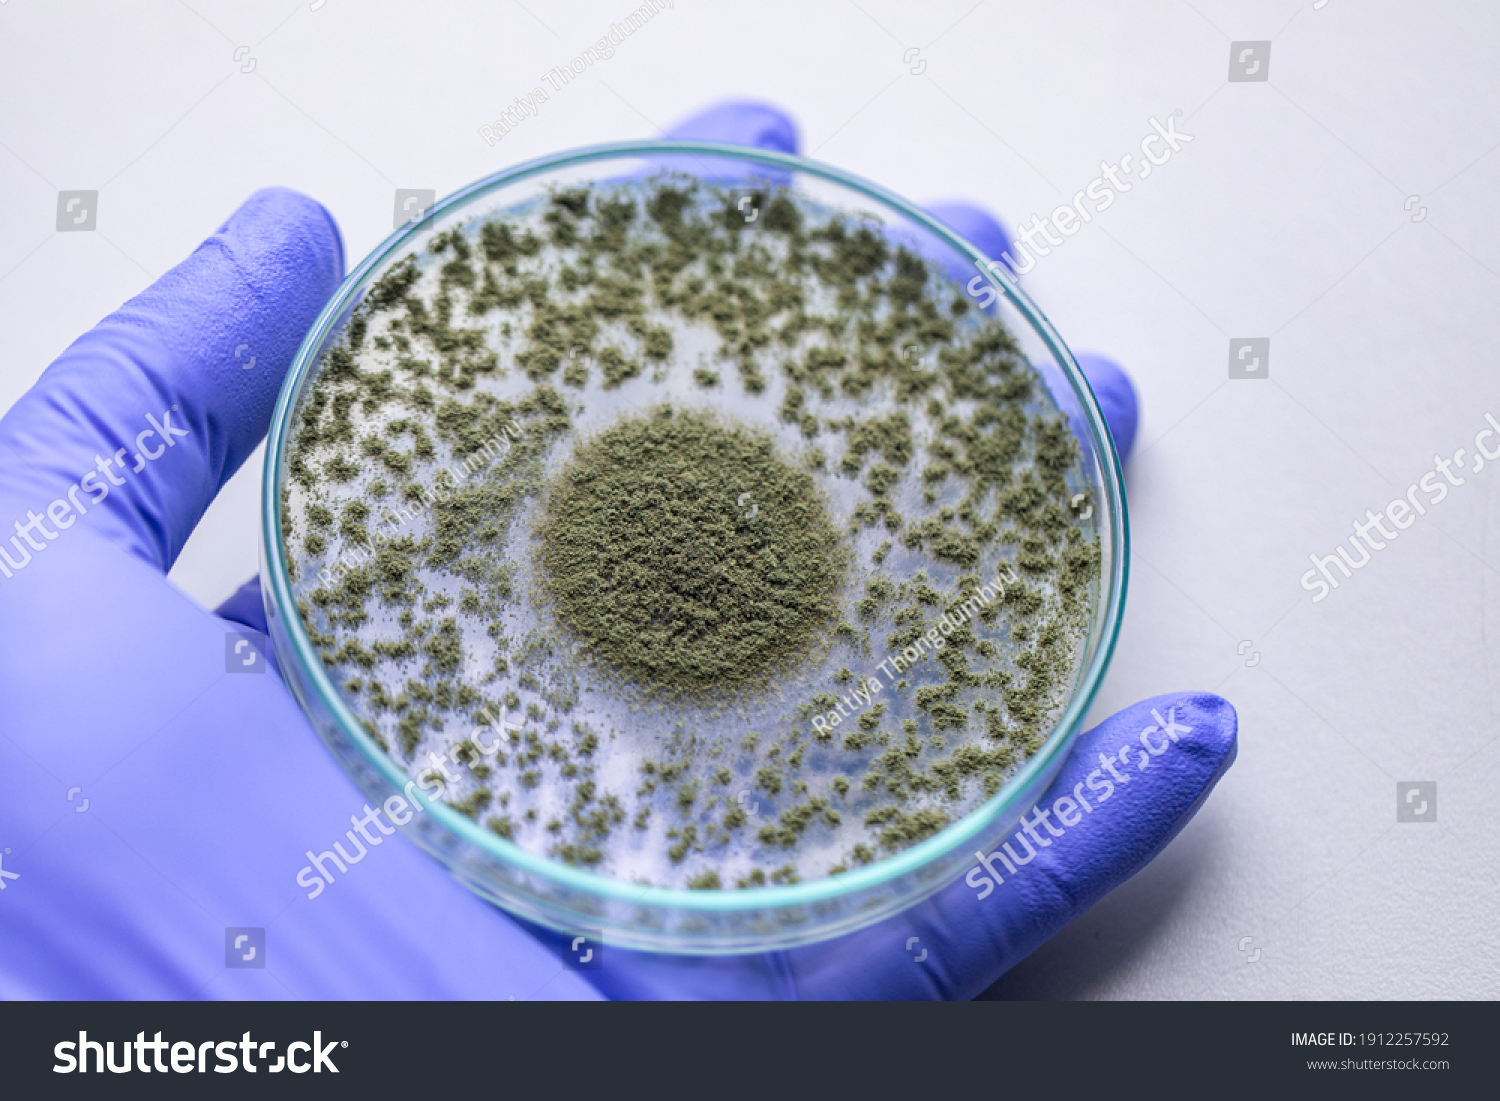

- Allergy tendency can run in families
- Symptoms range from mild to severe
- Major trigger for asthma and eczema
Are Allergies Common?
In India, allergies are on the rise and now affect over 30 crore people. Allergies can show up in many different ways—sometimes with mild symptoms like sneezing or itching, and other times with serious reactions that need immediate medical attention. They’re also a major trigger for conditions like asthma, hay fever (rhinitis), eczema (atopic dermatitis), and sinus problems.
What happens during an allergic reaction?
In people with allergies, the immune system mistakenly sees harmless substances—called allergens—as dangerous invaders. When the body comes into contact with an allergen, it triggers a chain reaction. Special white blood cells produce IgE antibodies, which attach to mast cells. These cells then release powerful chemicals like histamine, which cause typical allergy symptoms such as sneezing, itching, rashes, or even breathing problems.
Immune alert
IgE formed
Histamine release
Symptoms
What Causes Allergies?
There are a few key reasons why someone might develop allergies:
Genetics
Allergies often run in families. If one parent has allergies, their child has about a 50% chance of developing them too.
The Hygiene Hypothesis
Children who grow up in extremely clean environments with little exposure to germs may be more likely to develop allergies. Some exposure to bacteria and infections in early life may help the immune system develop normally.
What are Allergens?
An allergen is any substance that can cause an allergic reaction. It can enter the body through the air, skin, or food. Common types of allergens include:
Environmental
- Dust mites
- Pollen (from trees, weeds, and grasses)
- Mold or fungus spores
- Animal dander
Food Allergens
- Milk
- Eggs
- Peanuts and tree nuts
- Wheat and Soy
- Fish and shellfish
Allergy Symptoms
Allergic reactions can vary from mild to severe and may affect different parts of the body, depending on how the allergen enters:
Respiratory System
Sneezing, wheezing, coughing, or shortness of breath.
Skin
Rashes, itching, eczema, or hives.
Nose & Sinuses
Nasal congestion, runny nose, sinus pressure.
Digestive System
Stomach pain, vomiting, or diarrhea (especially with food allergies).
Types of Allergies
Food Allergy
An immune reaction to specific foods like milk, nuts, or seafood.
Skin Allergy
Causes rashes, itching, or eczema from contact with allergens.
Dust Allergy
Triggered by dust mites; often causes sneezing and nasal symptoms.
Eye Allergy
Leads to itchy, watery, red eyes due to airborne allergens.
Contact Dermatitis
A skin rash from touching substances like metals or cosmetics
Insect Sting Allergy
Allergic responses to bee, wasp, or ant stings.
Pet Allergy
Reaction to pet dander, saliva, or urine—common with cats and dogs.
Drug Allergy
Immune system reacts to medications like antibiotics or painkillers.
Allergic Rhinitis
Also known as hay fever; causes sneezing and congestion from pollen or dust.
Latex Allergy
Allergy to natural rubber products like gloves or balloons.
Mold Allergy
Caused by mold spores in damp areas, often affecting breathing
Cockroach Allergy
Triggered by proteins in cockroach waste and body parts.
Anaphylaxis & immune reaction types
Anaphylaxis
A severe, fast‑acting allergic reaction that can be life‑threatening and needs emergency treatment right away.
What happens in the body
- Immune system flags a harmless substance as a threat (allergen).
- IgE antibodies form and attach to mast cells.
- On re‑exposure, mast cells release chemicals like histamine.
- Symptoms appear: sneezing, itching, rashes, tummy upset, breathing trouble.
Diagnosis
Understanding your allergies starts with the right tests. From fast skin prick testing to advanced blood work, our specialists use safe and proven methods to identify exactly what’s triggering your symptoms. Proper diagnosis helps your allergist create the most effective treatment plan and improve your day-to-day life.
Treatments
If allergies are affecting your eyes, breathing, or daily comfort, there are multiple treatments that can help. Options range from quick solutions like antihistamines and eye drops to long-lasting treatments such as immunotherapy (allergy shots or under-the-tongue drops). You can also benefit from mast cell stabilizers and steroid-based therapies for stronger or persistent symptoms.
*Every allergy is different—and so is the treatment that works best for you.
Think You Have Allergies?
Don’t let allergies control your life. Get accurate diagnosis and personalized treatment to find long-term relief from your symptoms.